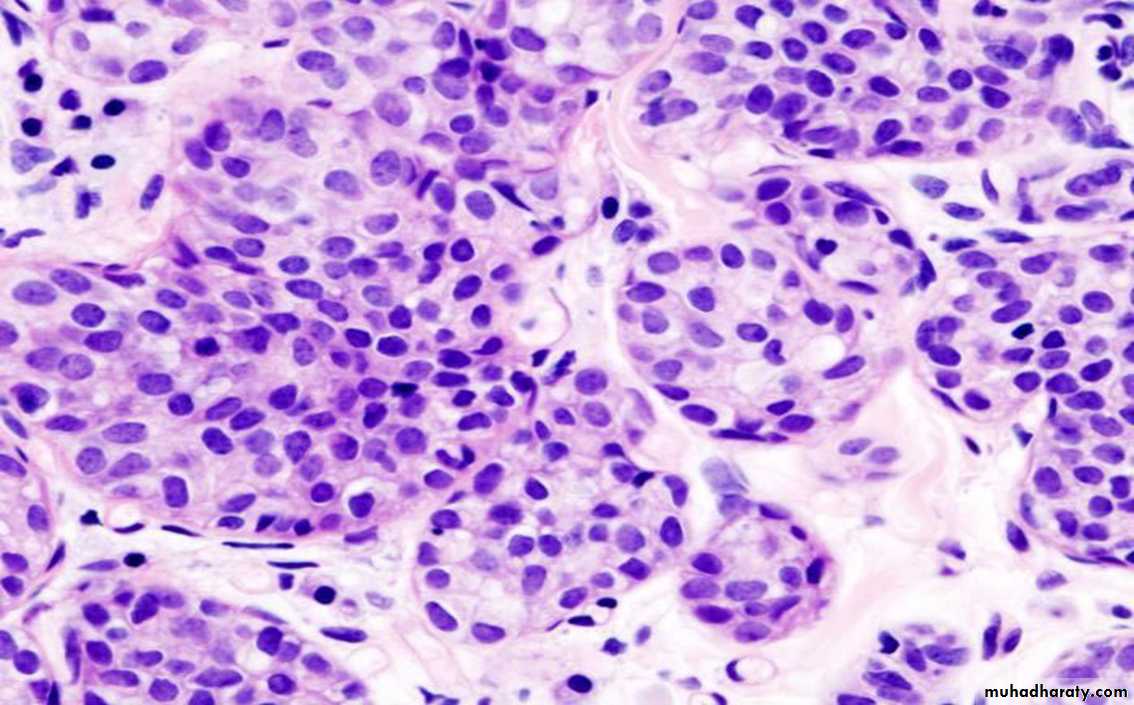

Breast
Dr. Sura Obay Al-DewachiCarcinoma
Breast cancer is the most common cancer in women.Risk factors
Age, rare before 25 years
Early menarche and late menopause
Age at 1st pregnancy
First-degree relatives with breast cancer
Prior breast biopsies with atypical hyperplasia
Additional risk factors
Hormone replacement therapy.Radiation exposure
Carcinoma of the contralateral breast or endometrium
Additional risk Factors
DietOver weight
Lack of exercise
Lack of breast feeding
Environmental toxins
smoking
Pathogenesis of breast cancer
Genetic influence:
approximately 5-10% of breast cancer are hereditary, meaning that there is a known genetic mutation causing increased cancer risk in the patient’s family.
25% are attributed to mutations in two supressor genes (BRCA1, BRCA2).
Other genes mutations form 10%.
Remaining 65% of familial breast cancers are unexplained.
Hormonal influence: risk of breast cancer increase with life time estrogen exposure, so hormonal imbalance (endogenous estrogens excess) play a significant role.
Role of estrogen in breast cancer
Its metabolites can cause mutation or generate DNA-damaging free radicals
Via its hormonal action, it directly stimulates proliferation of epithelial cells
Classification of breast carcinoma
The chief forms of carcinoma of breast can be classified as follow:Non invasive (in situ)(cancer not penetrate the limiting basemet membrane):
Ductal carcinoma in situ (DCIS) (intraductal carcinoma)
Lobular carcinoma in situ (LCIS)
Invasive (infiltrating)
Invasive ductal carcinomaInvasive lobular carcinoma
Medullary carcinoma
Colloid carcinoma (mucinous carcinoma)
Tubular carcinoma
Ductal carcinoma in situ (DCIS)
Forms up to 30% of all carcinomas.
Presents as
Vague palpable mass
Nipple discharge
Mammographic calcifications or densities
Incidental in a biopsy for another lesion
Majority of cases cannot be detected by palpation or visual inspection
Morphology (Comedocarcinoma, solid, cribriform, papillary, micropapillary)
Many cases will progress to invasive carcinoma
Mastectomy is curative in 95% of cases
• DCIS, comedo pattern
• Comedo carcinoma DCIS, solid pattern
• DCIS, cribriform pattern
• DCIS, papillary pattern
Paget disease of nipple
It is caused by extension of DCIS up to lactiferous ducts and in to the contiguous skin of the nipple.The clinical appearance is unilateral erythematous pruritic eruption , crusting exudate over the nipple and areolar skin.
About half of cases, an underlying invasive carcinoma will be found , and presented with palpable mass.
• Paget disease of nipple
•
Lobular Carcinoma In Situ (LCIS)
Always an incidental finding in a biopsy performed for another reasonMore common in young women
bilateral in up to 40% of cases
Management include
Bilateral prophylactic mastectomy
Tamoxifen
Close clinical follow-up and mammo-graphic screening
LCIS
Invasive Carcinoma
Almost always presents as a palpable mass• Invasive duct carcinoma
Invasive lobular carcinoma
• Spread of breast cancer :
• Direct : It invades the breast tissue & overlying skin with ulceration & nipple retraction . It may invade the underlying muscle & chest wall .• Lymphatics :
• Permeation of the local dermal lymphatics by tumour cause blockage of lymphatics & oedema of the skin producing a Peau d orange.
• Dermal lymphatic invasion may produce multiple tumour nodules with thickening of skin .
• Invasion of axillary lymph nodes .
• Invasion of internal mammary lymph nodes .
• Invasion of supraclavicular lymph nodes .
• Blood : spread to lung , liver & bones .
Major prognostic factors
In situ versus invasive carcinoma
distant metastasis
lymph node metastases
primary tumor size
locally advanced disease
inflammatory carcinoma
Invasion of chest wall
Skin ulceration
• THE MALE BREAST
• Gynaecomastia :• It is enlargement of the breast tissue of males ,which is usually caused by proliferation of connective tissue & ducts of the breast. It may be unilateral or bilateral .
• Aetiology :
• Endocrine disturbances : due to increase estrogen
• Testicular tumors e.g. teratoma.
• estrogen therapy e.g. for carcinoma of the prostate
• Cirrhosis : Due to failure of detoxification of estrogen .
• Drugs : e.g. digitalis , tricyclic compounds.
• GynecomastiaGynecomastia